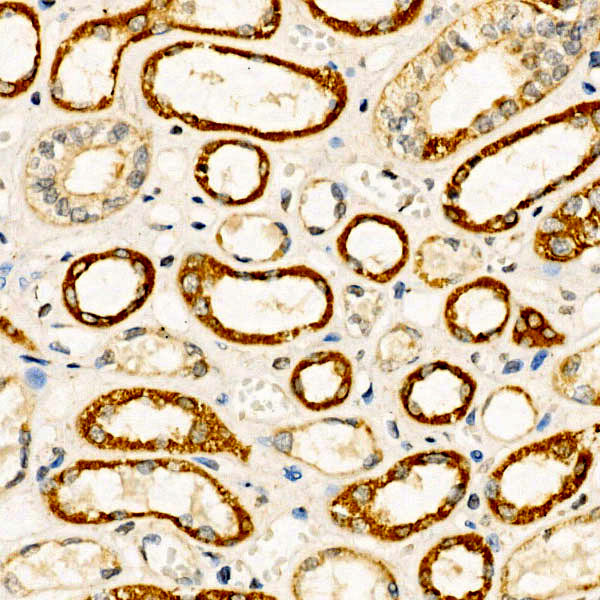

BMP7 Rabbit Polyclonal Antibody
| Cat Number: | AB0697 |
|---|---|
| Conjugate: | Unconjugated |
| Size: | 100 ug |
| Concentration: | 1mg/ml |
| Host: | Rabbit |
| Isotype: | IgG |
| Immunogen: | Recombinant protein.This information is considered to be commercially sensitive. |
| Reactivity: | Human,Mouse,Rat |
| Applications: | WB 1:500 - 1:1000 IHC-P 1:50 - 1:200 ELISA Recommended starting concentration is 1 μg/mL. Please optimize the concentration based on your specific assay requirements. |
| Molecular: | 49kDa |
| Purification: | Affinity purification |
| Synonyms: | OP-1; BMP7 |
| Background: | This gene encodes a secreted ligand of the TGF-beta (transforming growth factor-beta) superfamily of proteins. Ligands of this family bind various TGF-beta receptors leading to recruitment and activation of SMAD family transcription factors that regulate gene expression. The encoded preproprotein is proteolytically processed to generate each subunit of the disulfide-linked homodimer, which plays a role in bone, kidney and brown adipose tissue development. Additionally, this protein induces ectopic bone formation and may promote fracture healing in human patients. |
| Form: | liquid |
| Buffer: | PBS containing 50% glycerol, preserved with proclin300 or sodium azide (as specified on the Certificate of Analysis), pH 7.3. |
| Storage: | Store at -20℃. Avoid freeze / thaw cycles. |

Western blot analysis of various lysates using BMP7 Rabbit pAb at 1:1000 dilution.
Secondary antibody: HRP-conjugated Goat anti-Rabbit IgG (H+L) at 1:10000 dilution.
Lysates/proteins: 25μg per lane.
Blocking buffer: 3% nonfat dry milk in TBST.
Detection: ECLWest Pico Plus.
Exposure time: 1s.
Immunohistochemistry analysis of paraffin-embedded Human kidney using BMP7 Rabbit pAb at dilution of 1:50 (40x lens). High pressure antigen retrieval performed with 0.01M Citrate buffer (pH 6.0) prior to IHC staining.
